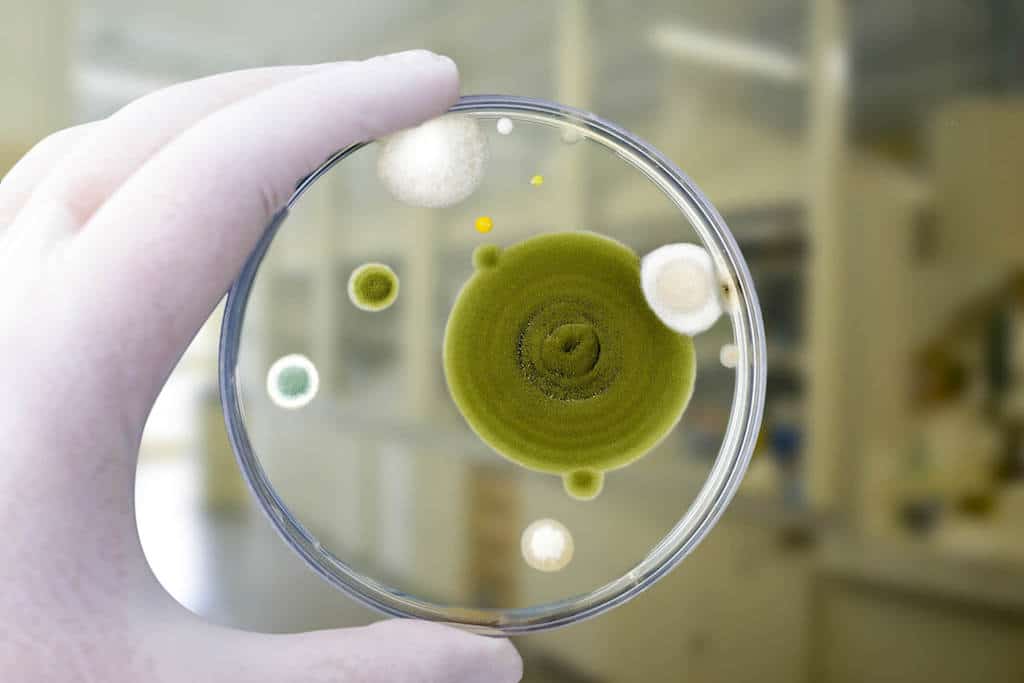

At the root, a carcinogenic is defined as something that has the ability to cause cancer. That C-word is one most of us are personally familiar with; either we know someone who suffered from cancer or we spend our lives actively avoiding things that could cause it in our own bodies.
Cigarettes, for instance, contain carcinogens.¹
When we spend so much time focusing on potentially carcinogenic aspects like diet, bathroom products, and even outdoor air pollution, but indoor air quality gets overlooked. Not to mention, the relationship between pre-existing cancer and air quality.
Ongoing research continues to study the relationship between mold exposure and cancer risk. At the moment, we just don’t know enough to draw a solid conclusion. What researchers have agreed to, though, is that mycotoxins are carcinogens.²’³ While the focus on mycotoxins rests mostly on their presence in food products,⁴ these microscopic toxins are produced by molds. Molds that could very well be in your home.⁵
That means these microscopic toxins could be floating around the air inside your house and landing on items like your couch, clothing, and countertops.
SO WHY FOCUS ON CANCER AND AIR QUALITY TOGETHER?
Debating the validity of whether or not molds and mycotoxins can cause cancer will more than likely continue for the next few years as researchers continue to study the relationship between exposure and health. What we can do right now is look at the facts we do know.
Mold exposure causes adverse health reactions.⁶ These fungi produce mycotoxins that can cause adverse health reactions.⁷ Exposure usually means a water leak, meaning bacteria may also be present from the damaged source; bacteria that can also cause adverse health reactions.⁸
For those undergoing cancer treatments, exposure to these microscopic organisms and toxins can have serious effects on an already downed immune system.
That’s why considering cancer and air quality is so important.
MOLD, POOR AIR QUALITY, AND YOUR HEALTH
Molds are a type of fungi that can exist both indoors and outdoors.⁹’¹⁰ They play a crucial part in nature by helping break down dead matter. But when they’re established in your home, they can wreak havoc on your health.
These fungi reproduce by creating microscopic spores that float through the air current and land on anything.¹¹ If they find areas with moisture, oxygen, and food, they’ll settle in and begin to colonize.¹²
The more they colonize, the more spores they create. When the home they made happens to be inside your house, all of those spores are floating through the air that you’re breathing. Add in the mycotoxins that many molds can produce, and your indoor air could be quickly filled with microscopic particulates all making their way into your lungs.
While mold exposure can affect anyone, some people are far more prone to experiencing symptoms immediately. Immunocompromised individuals are top on that list.
When an immune system is already weakened, it can’t handle the bombardment of foreign particles like mold spores, toxins, and bacteria. That’s why discussions of cancer and air quality should be much more prevalent.
For those undergoing cancer treatments, their immune systems have been completely compromised by chemotherapy and radiation.¹³ They’ve been left with no defense against poor air quality inside their home; their safe space.
Instead, the unseen particles are left with an open door to cause a wide range of health symptoms, including entire systemic reactions.
SYMPTOMS OF EXPOSURE CAN INCLUDE:¹⁴
- Chronic fatigue
- Neurological issues
- Joint pain
- Respiratory system issues
- Digestive issues
- Vertigo
- Rash
Experiencing cancer and cancer treatments is enough to deal with without these other potential symptoms being tacked on.

CANCER AND AIR QUALITY
There are several steps to take to help ensure a home is a safe haven for those undergoing cancer treatment. Air quality is often overlooked in creating a healthy environment, but that doesn’t mean the pattern has to continue! It just means we have to become our advocates for our own health and take preventative steps to ensure cleaner air in our homes.
TESTING A HOME
The first step towards creating a safe healing environment is to test the air quality in the home. Mold spores and mycotoxins are much smaller than the human eye can see and can float around a home completely undetected. You’ll need an inspector that prioritizes the health of those in the home and will meticulously test for any contaminants present.
The process itself should take a few hours and collect a broad spectrum of data including:
1. Types of molds present
2. Quantities of each mold
3. Potential spore presence in the HVAC system
4. Presence of mycotoxins (a harmful toxin produced by molds)
5. Presence of bacteria
This testing should act as a detailed map of the air in your home. You can’t see what’s in it, so what’s actually there? Does the inside of a home have a significantly larger number of mold spores than outside? Is there an abundance of mycotoxins? What kind of mold species are inside the home? Those questions need to be addressed before someone right out of chemotherapy comes inside to rest and recuperate.
REMEDIATE ANY ISSUES
If there are issues, you’ll need to find a remediation company that can tackle the job. What should that company look like?
Above all else, they should prioritize your health and the health of those in the home. Cancer and air quality should be a relationship they understand as highly important, and they shouldn’t leave until they’re satisfied that your home is safe.
Ultimately, a great remediation company should stand on three pillars for their treatment protocol.
One: remediate the sources of the mold properly
Two: identify and address the problems that led to the sources in the first place
Three: eradicate all of the contamination created by the sources
There’s also a great questionnaire sheet you can use when interviewing to help make sure the remediation company you choose can accomplish the job and has your best interests at heart.

TAKE PREVENTATIVE MEASURES
If the testing showed no clear problems, that’s fantastic! The next step should be making sure the air quality in your home remains clean.
These preventative actions can range from inspecting the roof and windows regularly to checking the vents in bathrooms and kitchens. While these actions may cost money upfront, they’ll help save money spent on remediation in the long run. Not to mention, they’ll help protect those with cancer against poor indoor air quality.
Another option to help ensure clean air is to invest in an air purifier. These machines have the ability to cleanse the air in your home of particles as small as .oo7 microns. That’s pretty small! And it happens to be around the size of particulates like mold spores, bacteria, and mycotoxins. Not all purifiers are built the same though, so make sure you choose one that is actually equipped to filter these microscopic organisms and toxins from the air.
These actions may seem like a lot, but they’re worth the effort to ensure better air quality and a safe indoor environment. As a society, we’re just not used to looking at the air we breathe inside homes. That doesn’t mean we can’t start though!
AN ENVIRONMENT FOR HEALING: FOCUSING ON CANCER AND AIR QUALITY
Getting a cancer diagnosis is terrifying. There are a million details to learn, steps to take, and minutes to get through. Not to mention the fear of the unknown and the psychological aspect of dealing with the disease. It’s easy to feel powerless during that time.
Something we can take control of during these times is the air quality in our homes. We can help create a clean, safe environment so that those suffering from cancer can focus on what’s important: healing.
If you or your loved one has cancer, please reach out to us. We’d be happy to help consult on building you a better environment to heal in. No one should have to deal with a recovery process disturbed by breathing in bad air.
- CDC. (2020, November 16). Tobacco and cancer. Centers for Disease Control and Prevention. https://www.cdc.gov/cancer/risk-factors/tobacco.html
- Ostry, V., Malir, F., Toman, J., & Grosse, Y. (2017). Mycotoxins as human carcinogens—the IARC Monographs classification. Mycotoxin research, 33(1), 65-73.
- Marasas, W. F., Gelderblom, W. C., Shephard, G. S., & Vismer, H. F. (2008). Mycotoxins: a global problem. In Mycotoxins: Detection methods, management, public health and agricultural trade (Vol. 1, pp. 29-36). Oxfordshire: CABI.
- Zain, M. E. (2011). Impact of mycotoxins on humans and animals. Journal of Saudi chemical society, 15(2), 129-144.
- WHO. (2018, May 9). Mycotoxins. World Health Organization. https://www.who.int/news-room/fact-sheets/detail/mycotoxins.
- Environmental Protection Agency. (n.d.). A Brief Guide to Mold, Moisture and Your Home . EPA. https://www.epa.gov/mold/brief-guide-mold-moisture-and-your-home..
- Centers for Disease Control and Prevention. (2020, August 11). Basic facts about mold and dampness. Centers for Disease Control and Prevention. https://www.cdc.gov/mold-health/about/index.html
- Kuhn, D. M., & Ghannoum, M. A. (2003). Indoor mold, toxigenic fungi, and Stachybotrys chartarum: infectious disease perspective. Clinical microbiology reviews, 16(1), 144-172.
- Bush, R. K., Portnoy, J. M., Saxon, A., Terr, A. I., & Wood, R. A. (2006). The medical effects of mold exposure. Journal of Allergy and Clinical Immunology, 117(2), 326-333.
- Bennett, J. W. (1987). Mycotoxins, mycotoxicoses, mycotoxicology andMycopathologia.
- University of Cincinnati Academic Health Center. (2012, June 19). Specific bacteria linked to indoor water-damage and mold identified. ScienceDaily. Retrieved August 26, 2021 from www.sciencedaily.com/releases/2012/06/120619230226.htm
- Lstiburek, J., Brennan, T., & Yost , N. (2002, January 15). Rr-0208: What you need to know about mold. Building Science Corporation. https://www.buildingscience.com/documents/reports/rr-0208-what-you-need-to-know-about-mold/view.
- The immune system and cancer. Cancer Research UK. (2021, February 8). https://www.cancerresearchuk.org/about-cancer/what-is-cancer/body-systems-and-cancer/the-immune-system-and-cancer.
- Environmental and Occupational Health Assessment Program , & Environmental and Occupational Health Assessment Program , & Health Science Section, Mold Basics for Primary Care Clinicians (2009). Hartford, CT; Connecticut Department of Public Health. , H. S. S., Mold Basics for Primary Care Clinicians 1–10 (2009). Hartford, CT; Connecticut Department of Public Health
Still Have Questions?
A member of our team is here to help! Click on “Get Started ➤” below to book a consultation with a member of the HOMECLEANSE team. We have a few quick questions that will help us put together a roadmap to solve or prevent all of your mold problems.
Two minutes of your time could lead to better health for you and your family.







